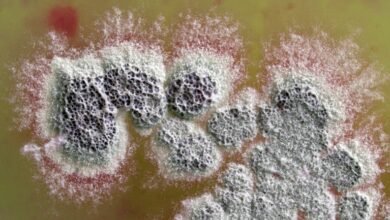

Месо које једу Американци који живе у градовима производи више ЦО2 од целе УК – али постоје лаки начини да се смањи
Месо које се конзумира у америчким градовима ствара еквивалент од 363 милиона тона (329 милиона метричких тона) емисије угљеника годишње, открива нова студија.
То је више од целокупне годишње емисије угљеника из УК од 336 милиона тона (305 милиона метричких тона).
Иако се процењује да становници градова једу отприлике сличне количине меса по особи у просеку широм САД, „угљенични отисак копита“ – гас стаклене баште емисије од конзумације говедине, свињетине и пилетине — значајно варирају у зависности од тога где и како се животиње узгајају и прерађују, према студији објављеној у понедељак (20. октобра) у часопису Природне климатске промене.
Пратећи руту од места где се храна за животиње производи све до места где се месо на крају једе, истраживачи су открили да је највећи отисак копита по особи – у Ричмонду, Мисури – више од три пута већи од најмањег отиска копита по особи, у Хотону, Мичиген.
Количина емитованих гасова стаклене баште значајно варира јер сваки град „има различите географске изворе и (постоје) различите производне праксе широм земље“, коаутор студије Бењамин Голдстеиндоцент за животну средину и одрживост на Универзитету у Мичигену, Анн Арбор, рекао је за Ливе Сциенце.
Иако су научници већ имали добру представу о отиску гасова стаклене баште у месу на регионалном или националном нивоу, потребне су информације на нивоу града за борбу против ових емисија, написали су истраживачи у студији.
Да би попунили ову празнину, научници су развили модел, који су делимично финансирале организације у сектору сточарства и малопродаје хране, који је мапирао ланац снабдевања месом за 3.531 град у континенталном делу САД, који покрива 93% америчке популације.
Тим је користио податке на нивоу округа из а национална анкета о здрављу и исхрани и попис становништва САД из 2017. како би се проценила количина меса која се конзумира по особи у сваком граду. Затим су реконструисали везе које повезују 3.143 округа који се баве производњом сточне хране, сточарством и прерадом меса са сваким градским подручјем.
Открили су да становници америчких градова сваке године поједу 5,1 милион тона (4,6 милиона метричких тона) пилетине, 4,1 милион тона (3,7 милиона метричких тона) говедине и 3 милиона тона (2,7 милиона метричких тона) свињског меса – стварајући комбиновани угљенични отисак копита од 362 милиона тона еквивалент угљен-диоксида. Ово је упоредиво са емисијом угљеника од домаће употребе фосилних горива у САД, која износи 368 милиона тона (334 милиона метричких тона).
Производња говеђег меса у просеку чини 73% отиска копита, али допринос варира у зависности од града, у зависности од тога да ли краве пасу или су у товилиштима. Интензитет емисије гасова стаклене баште за говеђе месо варира за фактор 4,3 у градовима, док пилетина варира за фактор 4,9, а свињетина за 15.
Разлике у производњи сточне хране су главни разлог за ову варијацију, укључујући и стопе примене азотног ђубрива и резултирајуће емисије азотног оксида, написали су истраживачи у студији.
Смањење или елиминисање потрошње говедине већ је препозната као важна за здравље наше планете. Ово ново истраживање открило је да би преполовљење отпада од јестиве хране, једење пилетине уместо говедине и дан без меса једном недељно смањило угљенични отисак копита у граду за 51% — што је „нетривијалан“ допринос усклађивању исхране са захтевима Париски споразум из 2015рекао је Голдстеин.
Док је студија разјаснила везе које повезују сеоске произвођаче хране и градске потрошаче, „рекао бих да широке контуре онога што треба да урадимо остају непромењене“, додао је Голдштајн. „Још увек не постоји таква ствар као што је крава са ниским садржајем угљеника.
Ану Рамасвамипрофесор грађевинског и еколошког инжењерства на Универзитету Принстон који није био укључен у истраживање, приметио је да је модел који су истраживачи развили у студији добро направљен и да је откривање варијација у отисцима копита у градовима „веома ново и проницљиво“.
Иако закључак да је производња говедине највећи емитер гасова стаклене баште није нов, истраживање наглашава да појединци не морају да постану вегани или вегетаријанци да би имали значајан утицај на угљенични отисак копита, рекла је она за Ливе Сциенце у мејлу. Предложени прелазак са говедине на друго месо је „одрживија“ дијететска интервенција од потпуног елиминисања меса, додао је Рамасвами.